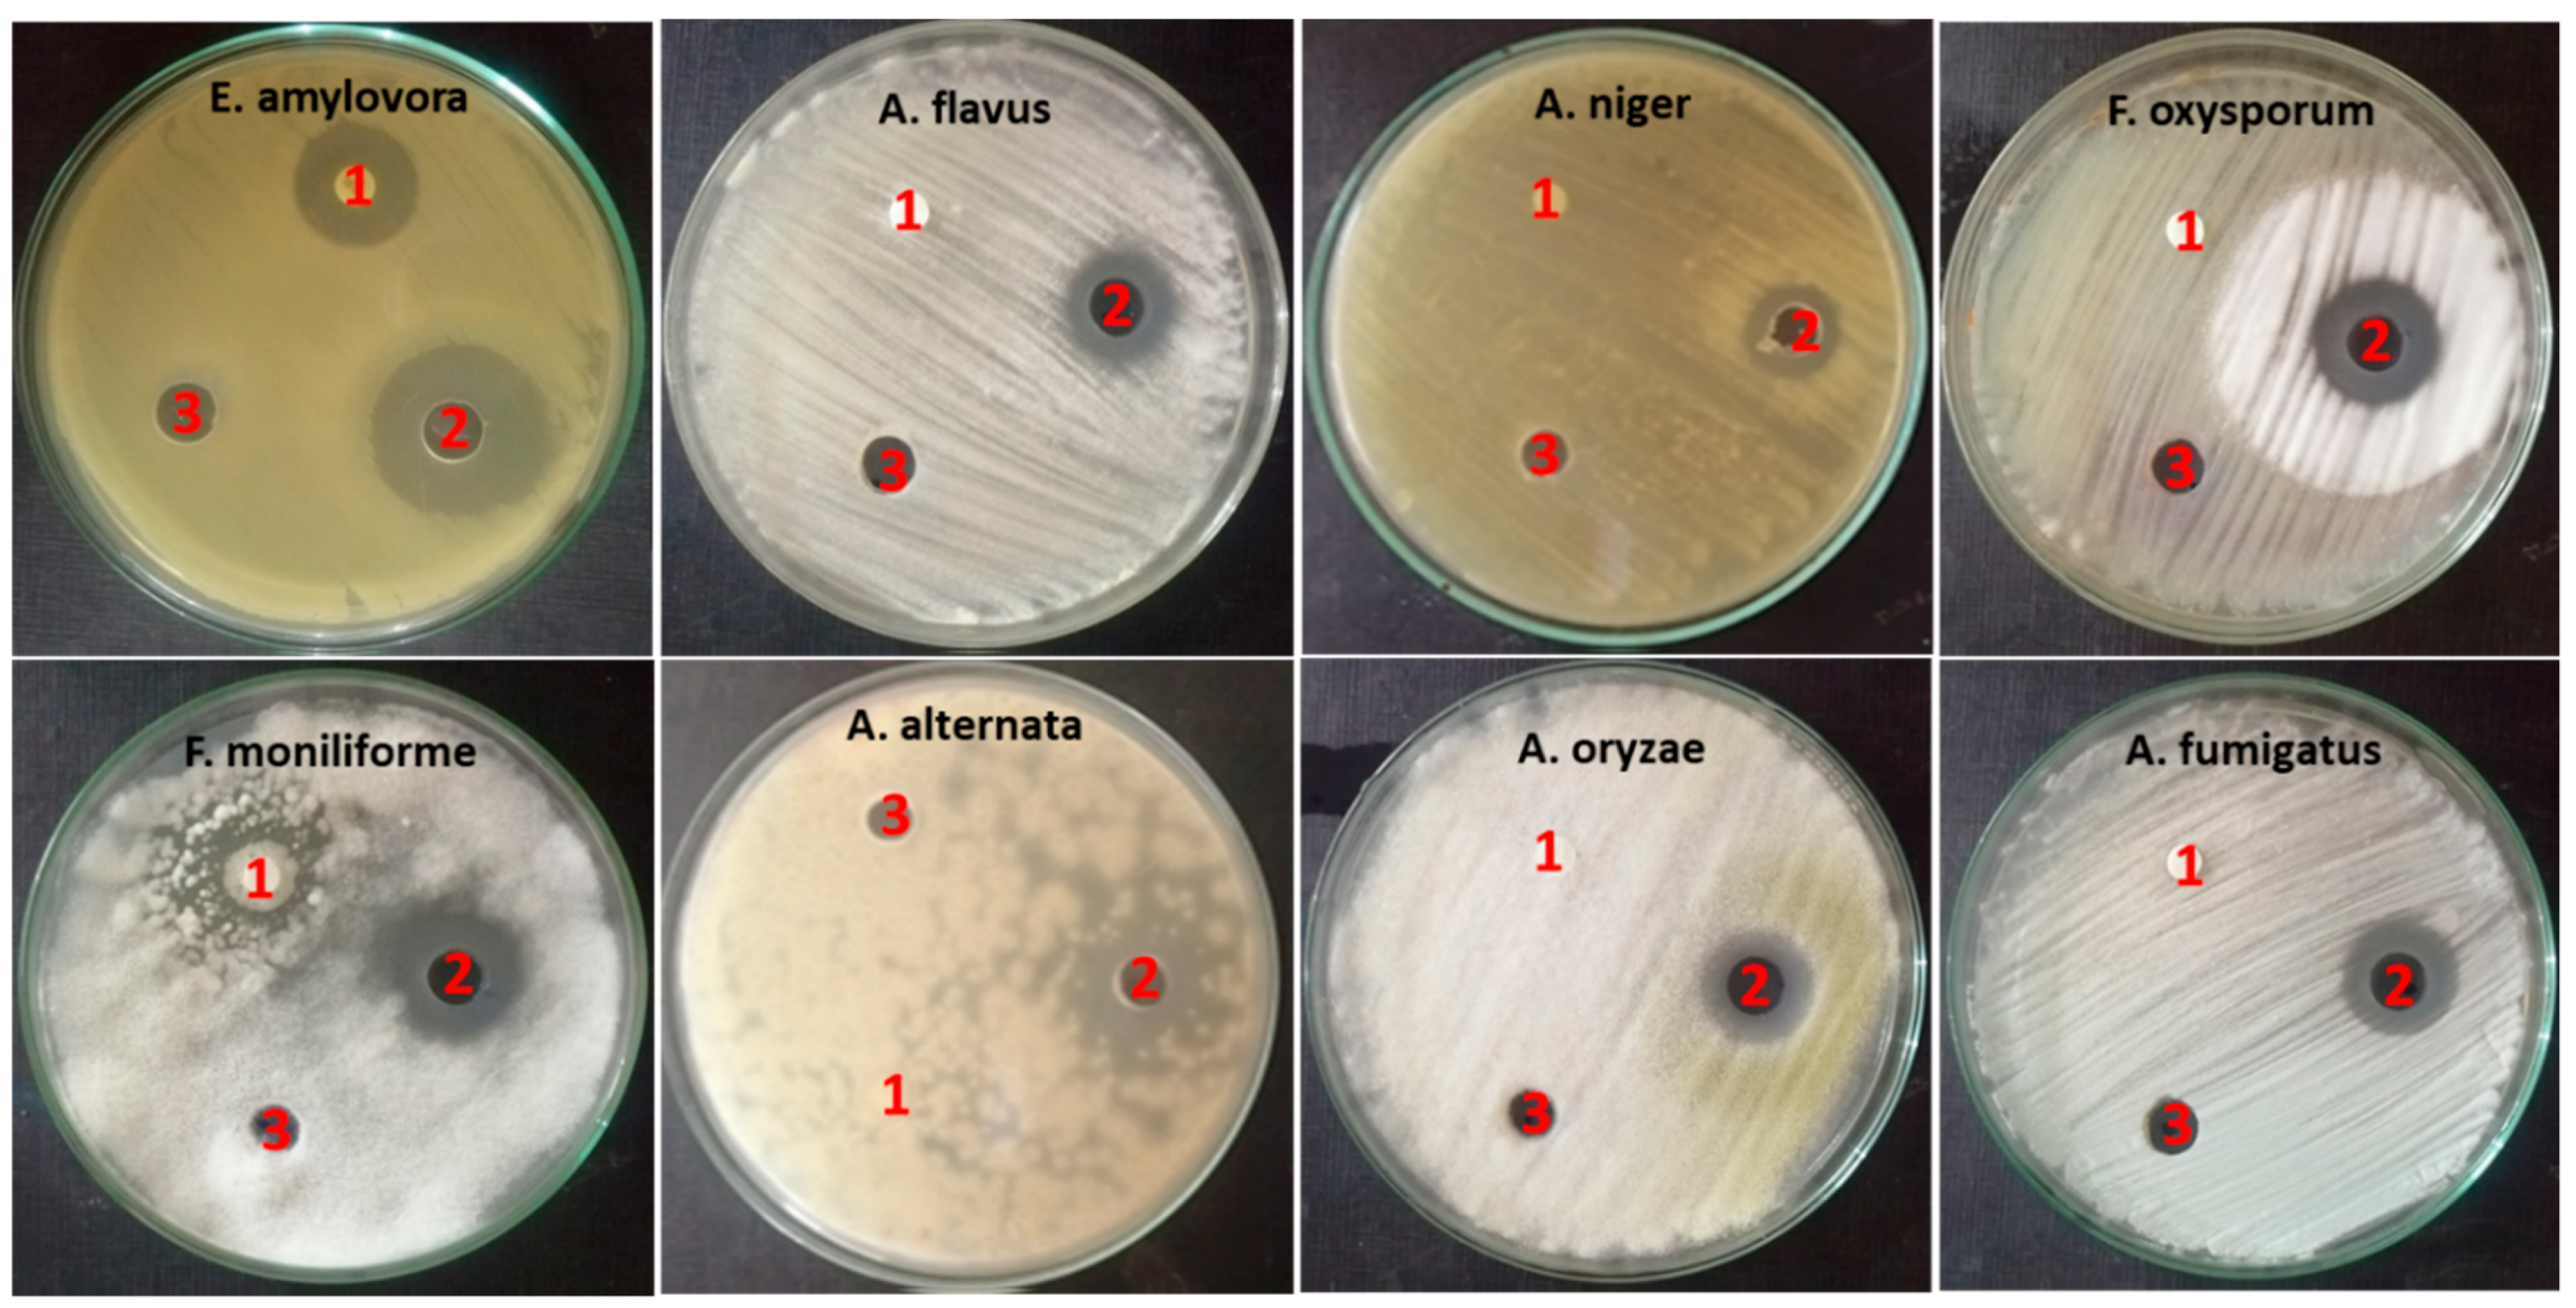

Green Synthesized ZnO Nanoparticles Mediated by Streptomyces plicatus: Characterizations, Antimicrobial and Nematicidal Activities and Cytogenetic Effects
Abstract
1. Introduction
2. Results
2.1. Isolation and Screening of Actinobacteria for Synthesis of Zinc Oxide Nanoparticles
2.2. Characterization of Biogenic ZnO-NPs
2.3. Identification of Isolate MK-104
2.4. Biological Activities of ZnO-NP Nanofluid
2.4.1. Antimicrobial Activity
2.4.2. Nematicidal Activity of ZnO-NP Nanofluid
2.5. Impact of ZnO-NPs on Germination and Seedling Vigor
2.6. Effect of ZnO-NPs on Mitotic Index and Chromosomal Aberration
3. Discussion
4. Materials and Methods
4.1. Isolation and Screening of Actinobacteria for the Biosynthesis of ZnO-NPs
4.2. Purification of Biosynthesized ZnO-NPs
4.3. Characterization of Biosynthesized ZnO-NPs
4.4. Identification of the Selected Actinobacterial Isolate
4.5. Preparation of ZnO-NP Nanofluid
4.6. Biological Activities of ZnO-NP Nanofluid
4.6.1. Antimicrobial Activity and Determination of the Minimum Inhibitory Concentration (MIC) of ZnO-NP Nanofluid
4.6.2. Determination of ZnO-NPs’ Nematicidal Activity by Mortality Assay of Meloidogyne incognita
4.7. Impact of ZnO-NP Nanofluid on Seed Germination Seedling Vigor Using V. faba Plant Model
4.8. Influence of ZnO-NPs on Cytological Characteristics of V. faba
4.9. Statistical Analysis
5. Conclusions
Author Contributions
Funding
Institutional Review Board Statement
Informed Consent Statement
Data Availability Statement
Acknowledgments
Conflicts of Interest
References
- Al-Dhabi, N.; Valan Arasu, M. Environmentally Friendly Green Approach for the Production of Zinc Oxide Nanoparticles and Their Anti-Fungal, Ovicidal, and Larvicidal Properties. Nanomaterials 2018, 8, 500. [Google Scholar] [CrossRef] [PubMed]
- Taner, M.; Sayar, N.; Yulug, I.G.; Suzer, S. Synthesis, Characterization and Antibacterial Investigation of Silver–Copper Nanoalloys. J. Mater. Chem. 2011, 21, 13150. [Google Scholar] [CrossRef]
- Wang, C.; Kim, Y.J.; Singh, P.; Mathiyalagan, R.; Jin, Y.; Yang, D.C. Green Synthesis of Silver Nanoparticles by Bacillus Methylotrophicus, and Their Antimicrobial Activity. Artif. Cells Nanomed. Biotechnol. 2016, 44, 1127–1132. [Google Scholar]
- Pandey, S.; Do, J.Y.; Kim, J.; Kang, M. Fast and Highly Efficient Catalytic Degradation of Dyes Using κ-Carrageenan Stabilized Silver Nanoparticles Nanocatalyst. Carbohydr. Polym. 2020, 230, 115597. [Google Scholar] [CrossRef]
- Pandey, S.; Ramontja, J. Sodium Alginate Stabilized Silver Nanoparticles–Silica Nanohybrid and Their Antibacterial Characteristics. Int. J. Biol. Macromol. 2016, 93, 712–723. [Google Scholar] [CrossRef]
- Ochieng, P.; Iwuoha, E.; Michira, I.; Masikini, M.; Ondiek, J.; Githira, P.; Kamau, G.N. Green Route Synthesis and Characterization of ZnO Nanoparticles Using Spathodea Campanulata. Int. J. Biochem. 2015, 23, 53–61. [Google Scholar]
- Barani, M.; Mukhtar, M.; Rahdar, A.; Sargazi, S.; Pandey, S.; Kang, M. Recent Advances in Nanotechnology-Based Diagnosis and Treatments of Human Osteosarcoma. Biosensors 2021, 11, 55. [Google Scholar] [CrossRef] [PubMed]
- Sabir, F.; Zeeshan, M.; Laraib, U.; Barani, M.; Rahdar, A.; Cucchiarini, M.; Pandey, S. DNA Based and Stimuli-Responsive Smart Nanocarrier for Diagnosis and Treatment of Cancer: Applications and Challenges. Cancers 2021, 13, 3396. [Google Scholar] [CrossRef] [PubMed]
- Pandey, S.; De Klerk, C.; Kim, J.; Kang, M.; Fosso-Kankeu, E. Eco Friendly Approach for Synthesis, Characterization and Biological Activities of Milk Protein Stabilized Silver Nanoparticles. Polymers 2020, 12, 1418. [Google Scholar] [CrossRef]
- Ojo, S.A.; Lateef, A.; Azeez, M.A.; Oladejo, S.M.; Akinwale, A.S.; Asafa, T.B.; Yekeen, T.A.; Akinboro, A.; Oladipo, I.C.; Gueguim-Kana, E.B.; et al. Biomedical and Catalytic Applications of Gold and Silver-Gold Alloy Nanoparticles Biosynthesized Using Cell-Free Extract of Bacillus Safensis LAU 13: Antifungal, Dye Degradation, Anti-Coagulant and Thrombolytic Activities. IEEE Trans. Nanobiosci. 2016, 15, 433–442. [Google Scholar] [CrossRef]
- Couto, E.A.A.; Dias-Arieira, C.R.; Kath, J.; Homiak, J.A.; Puerari, H.H.B.; Development, Z.I.E. Hatching and Reproduction of Meloidogyne Incognita. Acta Agric. Scand. Sect. B Soil Plant Sci. 2016, 66, 346–352. [Google Scholar]
- Golinska, P.; Wypij, M.; Ingle, A.P.; Gupta, I.; Dahm, H.; Rai, M. Biogenic Synthesis of Metal Nanoparticles from Actinomycetes: Biomedical Applications and Cytotoxicity. Appl. Microbiol. Biotechnol. 2014, 98, 8083–8097. [Google Scholar] [CrossRef]
- Zarina, A.; Nanda, A. Combined Efficacy of Antibiotics and Biosynthesised Silver Nanoparticles from Streptomyces Albaduncus. Int. J. Pharm. Technol. Res. 2014, 6, 1862–1869. [Google Scholar]
- Bhosale, R.S.; Hajare, K.Y.; Mulay, B.; Mujumdar, S.; Kothawade, M. Biosynthesis, Characterization and Study of Antimicrobial Effect of Silver Nanoparticles by Actinomycetes spp. Int. J. Curr. Microbiol. Appl. Sci. 2015, 2, 144–151. [Google Scholar]
- Mohamedin, A.; El-Naggar, N.E.-A.; Shawqi Hamza, S.; Sherief, A.A. Green Synthesis, Characterization and Antimicrobial Activities of Silver Nanoparticles by Streptomyces Viridodiastaticus SSHH-1 as a Living Nanofactory: Statistical Optimization of Process Variables. Curr. Nanosci. 2015, 11, 640–654. [Google Scholar] [CrossRef]
- Karthik, L.; Kumar, G.; Kirthi, A.V.; Rahuman, A.A.; Bhaskara Rao, K.V. Streptomyces sp. LK3 Mediated Synthesis of Silver Nanoparticles and Its Biomedical Application. Bioprocess Biosyst. Eng. 2014, 37, 261–267. [Google Scholar] [CrossRef] [PubMed]
- Lakshmi, P.T.V.; Priyanka, D.; Annamalai, A. Reduction of Silver Ions by Cell Free Extracts of Westiellopsis sp. Int. J. Biomater. 2015, 2015, 539494. [Google Scholar] [CrossRef] [PubMed][Green Version]
- Al-Ani, L.K.T.; Furtado, E.L. The Effect of Incompatible Plant Pathogens on the Host Plant. In Molecular Aspects of Plant Beneficial Microbes in Agriculture; Elsevier: Amsterdam, The Netherlands, 2020; pp. 47–57. [Google Scholar]
- Yang, J.; Hsiang, T.; Bhadauria, V.; Chen, X.-L.; Li, G. Plant Fungal Pathogenesis. Biomed. Res. Int. 2017, 2017, 9724283. [Google Scholar] [CrossRef] [PubMed]
- Borruso, L.; Salomone-Stagni, M.; Polsinelli, I.; Schmitt, A.O.; Benini, S. Conservation of Erwinia Amylovora Pathogenicity-Relevant Genes among Erwinia Genomes. Arch. Microbiol. 2017, 199, 1335–1344. [Google Scholar] [CrossRef] [PubMed]
- Ibrahim, I.K.A.; Mokbel, A.A.; Handoo, Z.A. Current Status of Phytoparasitic Nematodes and Their Host Plants in Egypt. Nematropica 2010, 40, 239–262. [Google Scholar]
- Ibrahim, I.K.A.; Mokbel, A.A.; Hammad, S.E. Host Suitability of Some Solanaceous Plant Cultivars to the Root-Knot Nematodes, Meloidogyne spp. Glob. Adv. Res. J. Agric. Sci. 2014, 3, 136–140. [Google Scholar]
- Imfeld, G.; Vuilleumier, S. Measuring the Effects of Pesticides on Bacterial Communities in Soil: A Critical Review. Eur. J. Soil Biol. 2012, 49, 22–30. [Google Scholar] [CrossRef]
- Kosma, P.; Ambang, Z.; Begoude, B.A.D.; Hoopen, G.M.T.; Kuate, J.; Akoa, A. Assessment of Nematicidal Properties and Phytochemical Screening of Neem Seed Formulations Using Radopholus Similis, Parasitic Nematode of Plantain in Cameroon. Crop Prot. 2011, 30, 733–738. [Google Scholar] [CrossRef]
- Rehman, S.; Jermy, B.R.; Akhtar, S.; Borgio, J.F.; Abdul Azeez, S.; Ravinayagam, V.; Al Jindan, R.; Alsalem, Z.H.; Buhameid, A.; Gani, A. Isolation and Characterization of a Novel Thermophile; Bacillus Haynesii, Applied for the Green Synthesis of ZnO Nanoparticles. Artif. Cells Nanomed. Biotechnol. 2019, 47, 2072–2082. [Google Scholar] [CrossRef]
- Rajput, V.D.; Minkina, T.; Fedorenko, A.; Chernikova, N.; Hassan, T.; Mandzhieva, S.; Sushkova, S.; Lysenko, V.; Soldatov, M.A.; Burachevskaya, M. Effects of Zinc Oxide Nanoparticles on Physiological and Anatomical Indices in Spring Barley Tissues. Nanomaterials 2021, 11, 1722. [Google Scholar] [CrossRef] [PubMed]
- Rosa, G.; López-Moreno, M.L.; Haro, D.; Botez, C.E.; Peralta-Videa, J.R.; Gardea-Torresdey, J.L. Effects of ZnO Nanoparticles in Alfalfa, Tomato, and Cucumber at the Germination Stage: Root Development and X-Ray Absorption Spectroscopy Studies. Pure Appl. Chem. 2013, 85, 2161–2174. [Google Scholar] [CrossRef]
- Jayarambabu, N.; Kumari, B.S.; Rao, K.V.; Prabhu, Y.T. Germination and Growth Characteristics of Mungbean Seeds (Vigna Radiata L.) Affected by Synthesized Zinc Oxide Nanoparticles. Int. J. Curr. Eng. Technol. 2014, 4, 2347–5161. [Google Scholar]
- Israel García-López, J.; Lira-Saldivar, R.H.; Zavala-García, F.; Olivares-Sáenz, E.; Niño-Medina, G.; Angélica Ruiz-Torres, N.; Méndez-Argüello, B.; Díaz-Barriga, E. Effects of Zinc Oxide Nanoparticles on Growth and Antioxidant Enzymes of Capsicum Chinense. Toxicol. Environ. Chem. 2018, 100, 560–572. [Google Scholar] [CrossRef]
- Misra, A.; Srivastava, A.K.; Srivastava, N.K.; Khan, A. Zn-Acquisition and Its Role in Growth, Photosynthesis, Photosynthetic Pigments, and Biochemical Changes in Essential Monoterpene Oil (s) of Pelargonium Graveolens. Photosynthetica 2005, 43, 153–155. [Google Scholar] [CrossRef]
- Eisvand, H.R.; Kamaei, H.; Nazarian, F. Chlorophyll Fluorescence, Yield and Yield Components of Bread Wheat Affected by Phosphate Bio-Fertilizer, Zinc and Boron under Late-Season Heat Stress. Photosynthetica 2018, 56, 1287–1296. [Google Scholar] [CrossRef]
- Tsonev, T.; Cebola Lidon, F.J. Zinc in Plants-an Overview. Emir. J. Food Agric. 2012, 24, 322–333. [Google Scholar]
- Sedghi, M.; Hadi, M.; Toluie, S.G. Effect of Nano Zinc Oxide on the Germination Parameters of Soybean Seeds under Drought Stress. Ann. West Univ. Timisoara Ser. Biol. 2013, 16, 73. [Google Scholar]
- Szőllősi, R.; Molnár, Á.; Kondak, S.; Kolbert, Z. Dual Effect of Nanomaterials on Germination and Seedling Growth: Stimulation vs. Phytotoxicity. Plants 2020, 9, 1745. [Google Scholar] [CrossRef] [PubMed]
- Tymoszuk, A.; Wojnarowicz, J. Zinc Oxide and Zinc Oxide Nanoparticles Impact on in Vitro Germination and Seedling Growth in Allium Cepa L. Materials 2020, 13, 2784. [Google Scholar] [CrossRef] [PubMed]
- Vidya, P.; Arulpandi, I. A Study on Evaluation of Antimicrobial Property of Biologically Synthesized Silver and Zinc Oxide Nanoparticles against Human Pathogens. World J. Pharm. Sci. 2016, 4, 183–194. [Google Scholar]
- Ehsan, S.; Sajjad, M. Bioinspired Synthesis of Zinc Oxide Nanoparticle and Its Combined Efficacy with Different Antibiotics against Multidrug Resistant Bacteria. J. Biomater. Nanobiotechnol. 2017, 08, 159–175. [Google Scholar] [CrossRef][Green Version]
- Yusof, H.M.; Mohamad, R.; Zaidan, U.H.; Samsudin, A.A. Biosynthesis of Zinc Oxide Nanoparticles by Cell-Biomass and Supernatant of Lactobacillus Plantarum TA4 and Its Antibacterial and Biocompatibility Properties. Sci. Rep. 2020, 10, 1–13. [Google Scholar]
- Mohamed Yusof, H.; Mohamad, R.; Zaidan, U.H.; Abdul Rahman, N.A. Microbial Synthesis of Zinc Oxide Nanoparticles and Their Potential Application as an Antimicrobial Agent and a Feed Supplement in Animal Industry: A Review. J. Anim. Sci. Biotechnol. 2019, 10. [Google Scholar] [CrossRef]
- Mostafaei, A.; Zolriasatein, A. Synthesis and Characterization of Conducting Polyaniline Nanocomposites Containing ZnO Nanorods. Prog. Nat. Sci. 2012, 22, 273–280. [Google Scholar] [CrossRef]
- Tiwari, V.; Mishra, N.; Gadani, K.; Solanki, P.S.; Shah, N.A.; Tiwari, M. Mechanism of Anti-Bacterial Activity of Zinc Oxide Nanoparticle against Carbapenem-Resistant Acinetobacter Baumannii. Front. Microbiol. 2018, 9. [Google Scholar] [CrossRef]
- Ashe, B. A Detail Investigation to Observe the Effect of Zinc Oxide and Silver Nanoparticles in Biological System. Master’s Thesis, Department of Biotechnology and Medical Engineering, National Institute of Technology, Orissa, India, 2011. [Google Scholar]
- Saliani, M.; Jalal, R.; Kafshdare Goharshadi, E. Effects of PH and Temperature on Antibacterial Activity of Zinc Oxide Nanofluid against Escherichia Coli O157: H7 and Staphylococcus Aureus. Jundishapur J. Microbiol. 2015, 8, e17115. [Google Scholar] [CrossRef]
- Kapoor, R.T.; Salvadori, M.R.; Rafatullah, M.; Siddiqui, M.R.; Khan, M.A.; Alshareef, S.A. Explo-ration of Microbial Factories for Synthesis of Nanoparticles—A Sustainable Approach for Bioremediation of Environmental Contaminants. Front. Microbiol. 2021, 12, 658294. [Google Scholar] [CrossRef]
- Dhoble, S.M.; Kulkarni, N.S. Biosynthesis and Characterization of Different Metal Nanoparticles by Using Fungi. Sch. Acad. J. Biosci. 2016, 4, 1022–1031. [Google Scholar]
- Khana, M.; Naqvib, A.H.; Ahmada, M. Comparative Study of the Cytotoxic and Genotoxic Potentials of Zinc Oxide and Titanium Dioxide Nanoparticles. Toxicol. Rep. 2015, 2, 765–774. [Google Scholar] [CrossRef]
- Honary, S.; Barabadi, H.; Gharaei-Fathabad, E.; Naghibi, F. Green Synthesis of Copper Oxide Nanoparticles Using Penicillium Aurantiogriseum, Penicillium Citrinum and Penicillium Waksmanii. Dig. J. Nanomater. Biostruct. 2012, 7, 999–1005. [Google Scholar]
- Saied, E.; Eid, A.; Hassan, S.; Salem, S.; Radwan, A.; Halawa, M.; Saleh, F.; Saad, H.; Saied, E.; Fou-da, A. The Catalytic Activity of Biosynthesized Magnesium Oxide Nanoparticles (MgO-NPs) for Inhibiting the Growth of Pathogenic Microbes, Tanning Effluent Treatment, and Chromium Ion Removal. Catalysts 2021, 11, 821. [Google Scholar] [CrossRef]
- Williams, S.T.; Goodfellow, M.; Alderson, G. Genus Streptomyces Waksman and Henrici 1943, 339AL; Williams, S.T., Sharpe, M.E., Holt, J.G., Eds.; Williams and Willkins: Baltimore, MD, USA, 1989; Volume 4, pp. 2453–2492. [Google Scholar]
- Hensyl, W.R. Bergey’s Manual of Systematic Bacteriology, 9th ed.; Springer: Berlin/Heidelberg, Germany, 1994. [Google Scholar]
- Sirelkhatim, A.; Mahmud, S.; Seeni, A.; Kaus, N.H.M.; Ann, L.C.; Bakhori, S.K.M.; Hasan, H.; Mohamad, D. Review on Zinc Oxide Nanoparticles: Antibacterial Activity and Toxicity Mechanism. Nanomicro Lett. 2015, 7, 219–242. [Google Scholar] [CrossRef] [PubMed]
- Jamdagni, P.; Khatri, P.; Rana, J.S. Green Synthesis of Zinc Oxide Nanoparticles Using Flower Extract of Nyctanthes Arbor-Tristis and Their Antifungal Activity. J. King Saud Univ. Sci. 2018, 30, 168–175. [Google Scholar] [CrossRef]
- Agarwal, H.; Menon, S.; Venkat Kumar, S.; Rajeshkumar, S. Mechanistic Study on Antibacterial Action of Zinc Oxide Nanoparticles Synthesized Using Green Route. Chem. Biol. Interact. 2018, 286, 60–70. [Google Scholar] [CrossRef] [PubMed]
- Seil, J.T.; Webster, T.J. Antimicrobial Applications of Nanotechnology: Methods and Literature. Int. J. Nanomed. 2012, 7, 2767–2781. [Google Scholar]
- Jayaseelan, C.; Rahuman, A.A.; Kirthi, A.V.; Marimuthu, S.; Santhoshkumar, T.; Bagavan, A.; Gaurav, K.; Karthik, L.; Rao, K.V.B. Novel Microbial Route to Synthesize ZnO Nanoparticles Using Aeromonas Hydrophila and Their Activity against Pathogenic Bacteria and Fungi. Spectrochim. Acta A Mol. Biomol. Spectrosc. 2012, 90, 78–84. [Google Scholar] [CrossRef] [PubMed]
- He, L.; Liu, Y.; Mustapha, A.; Lin, M. Antifungal Activity of Zinc Oxide Nanoparticles against Botrytis Cinerea and Penicillium Expansum. Microbiol. Res. 2011, 166, 207–215. [Google Scholar] [CrossRef] [PubMed]
- Palanikumar, L.; Ramasamy, S.N.; Balachandran, C. Size-Dependent Antimicrobial Response of Zinc Oxide Nanoparticles. IET Nanobiotechnol. 2014, 8, 111–117. [Google Scholar] [CrossRef] [PubMed]
- Rajendran, N.K.; George, B.P.; Houreld, N.N.; Abrahamse, H. Synthesis of Zinc Oxide Nanoparticles Using Rubus Fairholmianus Root Extract and Their Activity against Pathogenic Bacteria. Molecules 2021, 26, 3029. [Google Scholar] [CrossRef]
- Khalil, A.; Rahhal, M.; El-Korany, A.E.; Balbaa, E.M. Effect of Certain Nanoparticles against Rootknotnematode, Meloidogyne Incognita, Affecting, Tomato Plants in El-Behera Governorate. J. Agric. Environ. Sci. Damanhur Univ. 2018, 17, 1–34. [Google Scholar]
- Page, A.P.; Johnstone, I.L. The Cuticle. WormBook. 2007; pp. 1–15. Available online: https://www.ncbi.nlm.nih.gov/books/NBK19745 (accessed on 17 August 2021).
- Youssef, M.S.; Elamawi, R.M. Evaluation of Phytotoxicity, Cytotoxicity, and Genotoxicity of ZnO Nanoparticles in Vicia Faba. Environ. Sci. Pollut. Res. Int. 2020, 27, 18972–18984. [Google Scholar] [CrossRef]
- Upadhyaya, H.; Roy, H.; Shome, S.; Tewari, S.; Bhattacharya, M.; Panda, S.K. Physiological Impact of Zinc Nanoparticle on Germination of Rice (Oryza Sativa L) Seed. J. Plant Sci. Phytopathol. 2017, 1, 062–070. [Google Scholar]
- Raskar, S.V.; Laware, S.L. Effect of Zinc Oxide Nanoparticles on Cytology and Seed Germination in Onion. Int. J. Curr. Microbiol. Appl. Sci. 2014, 3, 467–473. [Google Scholar]
- Adhikari, S.; Adhikari, A.; Ghosh, S. Assessment of ZnO- NPs Toxicity in Maize: An Integrative Mi-croRNAomic Ap- Proach. Chemosphere 2020, 249, 126197. [Google Scholar] [CrossRef]
- Raliya, R.; Tarafdar, J.C. ZnO Nanoparticle Biosynthesis and Its Effect on Phosphorous-Mobilizing Enzyme Secretion and Gum Contents in Clusterbean (Cyamopsis Tetragonoloba L.). Agric. Res. 2013, 2, 48–57. [Google Scholar] [CrossRef]
- Raliya, R.; Nair, R.; Chavalmane, S.; Wang, W.-N.; Biswas, P. Mechanistic Evaluation of Translocation and Physiological Impact of Titanium Dioxide and Zinc Oxide Nanoparticles on the Tomato (Solanum Lycopersicum L.) Plant. Metallomics 2015, 7, 1584–1594. [Google Scholar] [CrossRef]
- Lin, Y.-F.; Aarts, M.G.M. The Molecular Mechanism of Zinc and Cadmium Stress Response in Plants. Cell. Mol. Life Sci. 2012, 69, 3187–3206. [Google Scholar] [CrossRef]
- Hu, Y.; Tan, L.; Zhang, S.-H.; Zuo, Y.-T.; Han, X.; Liu, N.; Lu, W.-Q.; Liu, A.-L. Detection of Genotoxic Effects of Drinking Water Disinfection By-Products Using Vicia Faba Bioassay. Environ. Sci. Pollut. Res. Int. 2017, 24, 1509–1517. [Google Scholar] [CrossRef]
- Linnainmaa, K.; Meretoja, T.; Sorsa, M.; Vainio, H. Cytogenetic Effects of Styrene and Styrene Oxide. Mutat. Res. Rev. Genet. Toxicol. 1978, 58, 277–286. [Google Scholar] [CrossRef]
- Marcano, L.; Carruyo, I.; Del Campo, A.; Montiel, X. Cytotoxicity and Mode of Action of Maleic Hydrazide in Root Tips of Allium Cepa L. Environ. Res. 2004, 94, 221–226. [Google Scholar] [CrossRef]
- Kumari, M.; Khan, S.S.; Pakrashi, S.; Mukherjee, A.; Chandrasekaran, N. Cytogenetic and Genotoxic Effects of Zinc Oxide Nanoparticles on Root Cells of Allium Cepa. J. Hazard. Mater. 2011, 190, 613–621. [Google Scholar] [CrossRef]
- Taranath, T.C.; Patil, B.N.; Santosh, T.U.; Sharath, B.S. Cytotoxicity of Zinc Nanoparticles Fabricated by Justicia Adhatoda L. on Root Tips of Allium Cepa L.—A Model Approach. Environ. Sci. Pollut. Res. Int. 2015, 22, 8611–8617. [Google Scholar] [CrossRef]
- Ghosh, M.; Jana, A.; Sinha, S.; Jothiramajayam, M.; Nag, A.; Chakraborty, A.; Mukherjee, A.; Mukherjee, A. Effects of ZnO Nanoparticles in Plants: Cytotoxicity, Genotoxicity, Deregulation of Antioxidant Defenses, and Cell-Cycle Arrest. Mutat. Res. Genet. Toxicol. Environ. Mutagen. 2016, 807, 25–32. [Google Scholar] [CrossRef] [PubMed]
- El-Ghamery, A.A.; El-Nahas, A.I.; Mansour, M.M. The Action of Atrazine Herbicide as an Inhibitor of Cell Division on Chromosomes and Nucleic Acids Content in Root Meristems of Allium Cepa and Vicia Faba. Cytologia 2000, 65, 277–287. [Google Scholar] [CrossRef]
- Badr, A. Effects of the S-Triazine Herbicide Turbutryn on Mitosis, Chromosomes and Nucleic Acids in Root Tips of Vicia Faba. Cytologia 1986, 51, 571–577. [Google Scholar] [CrossRef]
- Nwakanma, N.M.C.; Okoli, B.E. Cytological Effects of the Root Extracts of Boerhaavia Diffusa on Roots Tips of Crinum Jagus. EuroAsia J. Biol. Sci. 2010, 4, 105–111. [Google Scholar] [CrossRef]
- Zou, J.H.; Wang, M.; Jiang, W.S.; Liu, D.H. Effects of Hexavalent Chromium (VI) on Root Growth and Cell Division in Root Tip Cells of Amaranthus Viridis L. Pak. J. Bot. 2006, 38, 673. [Google Scholar]
- Manzo, S.; Rocco, A.; Carotenuto, R.; Picione, F.D.L.; Miglietta, M.L.; Rametta, G.; Di Francia, G. Investigation of ZnO Nanoparticles’ Ecotoxicological Effects towards Different Soil Organisms. Environ. Sci. Pollut. Res. Int. 2011, 18, 756–763. [Google Scholar] [CrossRef] [PubMed]
- Kumari, N.; Abha, A.; Jha, A.M. Genotoxicity Testing of Food Additives by Employing Vicia MN Assay. J. Phytol. 2012, 4, 42–45. [Google Scholar]
- Venkatachalam, P.; Priyanka, N.; Manikandan, K.; Ganeshbabu, I.; Indiraarulselvi, P.; Geetha, N.; Mu-ralikrishna, K.; Bhattacharya, R.C.; Tiwari, M.; Sharma, N.; et al. Enhanced Plant Growth Promoting Role of Phycomolecules Coated Zinc Oxide Nanoparticles with P Supplementation in Cotton (Gossypium Hirsutum L.). Plant Physiol. Biochem. 2017, 110, 118–127. [Google Scholar] [CrossRef] [PubMed]
- Aslani, F.; Bagheri, S.; Muhd Julkapli, N.; Juraimi, A.S.; Hashemi, F.S.G.; Baghdadi, A. Effects of Engineered Nanomaterials on Plants Growth: An Overview. Sci. World J. 2014, 2014, 641759. [Google Scholar] [CrossRef]
- Sineva, O.N.; Terekhova, L.P. Selective isolation of rare Actinomycetes from soil. Antibiot. Khimioter. 2015, 60, 27–33. [Google Scholar] [PubMed]
- Ashajyothi, C.; Harish, K.H.; Dubey, N.; Chandrakanth, R.K. Antibiofilm Activity of Biogenic Copper and Zinc Oxide Nanoparticles-Antimicrobials Collegiate against Multiple Drug Resistant Bacteria: A Nanoscale Approach. J. Nanostruct. Chem. 2016, 6, 329–341. [Google Scholar] [CrossRef]
- Singh, M.; Kumar, M.; Kalaivani, R.; Manikandan, S.; Kumaraguru, A.K. Metallic Silver Nanoparticle: A Therapeutic Agent in Combination with Antifungal Drug against Human Fungal Pathogen. Bioprocess Biosyst. Eng. 2013, 36, 407–415. [Google Scholar] [CrossRef]
- Janice, L.J.; Wong, W.Y.; Rashmi, W.; Kadhum, A.A.; Mohamad, A.B. Synthesis of Zinc Oxide Nanoparticles Using Liquid-Phase Laser Ablation and Its Antibacterial Activity. J. Eng. Sci. Technol. 2017, 5, 29–43. [Google Scholar]
- Rajendran, S.P.; Sengodan, K. Synthesis and Characterization of Zinc Oxide and Iron Oxide Nanoparticles Using Sesbania Grandiflora Leaf Extract as Reducing Agent. J. Nanosci. 2017, 2017, 8348507. [Google Scholar] [CrossRef]
- Kavitha, S.; Dhamodaran, M.; Prasad, R.; Ganesan, M. Synthesis and Characterisation of Zinc Oxide Nanoparticles Using Terpenoid Fractions of Andrographis Paniculata Leaves. Int. Nano Lett. 2017, 7, 141–147. [Google Scholar] [CrossRef]
- Marsalek, R. Particle Size and Zeta Potential of ZnO. APCBEE Procedia 2014, 9, 13–17. [Google Scholar] [CrossRef]
- Moghannem, S.A.; El-Sherbiny, G.M.; Kalaba, M.H. Isolation and Identification of Streptomyces Baarnensis Mh-133 Produce Bioactive Metabolite Inhibiting Multidrug Resistant Bacteria (MDRB). World J. Pharm. Med. 2017, 3, 64–75. [Google Scholar]
- Kim, M.C.; Lee, J.; Kim, D.H.; Son, H.J.; Heo, M.S. Isolation and Identification of Antioxidant Producing Marine Source Actinomycetes and Optimal Medium Conditions. Food Sci. Biotechnol. 2014, 23, 1629–1635. [Google Scholar] [CrossRef]
- Shirling, E.B.; Gottlieb, D. Cooperative Description of Type Cultures of STREPTOMYCES III. Additional Species Descriptions from First and Second Studies. Int. J. Syst. Bacteriol. 1968, 18, 279–392. [Google Scholar] [CrossRef][Green Version]
- Soundari, A.; Parimala, G.; Rubini, G.; Manon Mani, V.; Brindha Priyadarisini, V. Study on Diversity of Actinomycetes Population from Industrial Area. Int. J. Curr. Microbiol. App. Sci. 2015, 4, 500–512. [Google Scholar]
- Bergey, D.H.; John, G.H. Bergey’s Manual of Determinative Biology, 9th ed.; William and Wilkins: Philadelphia, PA, USA, 1994; Chapter 4; pp. 181–186. [Google Scholar]
- Atta, H.M.; Bayoumi, R.; El-Sehrawi, M.; Galal, G.F. Taxonomic Studies and Phylogenetic Characterization of Streptomyces Remosus—KH-1223- 55 Isolated from AlKhurmah Governorate, KSA. Researcher 2011, 3, 27–40. [Google Scholar]
- Sharaf, M.H.; El-Sherbiny, G.M.; Moghannem, S.A.; Abdelmonem, M.; Elsehemy, I.A.; Metwaly, A.M.; Kalaba, M.H. New Combination Approaches to Combat Methicillin-Resistant Staphylococcus Aureus (MRSA). Sci. Rep. 2021, 11, 1–16. [Google Scholar] [CrossRef]
- Pulit-Prociak, J.; Staroń, A.; Prokopowicz, M.; Magielska, K.; Banach, M. Analysis of Antimicrobial Properties of PVA-Based Coatings with Silver and Zinc Oxide Nanoparticles. J. Inorg. Organomet. Polym. Mater. 2021, 31, 2306–2318. [Google Scholar] [CrossRef]
- Clinical and Laboratory Standards Institute (CLSI). Performance Standards for Antimicrobial Susceptibility Testing M100, 27th ed.; Replaces M100-S26; Clinical and Laboratory Standards Institute: Wayne, PA, USA, 2021. [Google Scholar]
- Perez, C.; Paul, M.; Bazerque, P. An Antibiotic Assay by the Agar Well Diffusion Method. Acta Biol. Med. Exp. 1990, 15, 113–115. [Google Scholar]
- Magaldi, S.; Mata-Essayag, S.; Hartung de Capriles, C.; Perez, C.; Colella, M.T.; Olaizola, C.; Ontiveros, Y. Well Diffusion for Antifungal Susceptibility Testing. Int. J. Infect. Dis. 2004, 8, 39–45. [Google Scholar] [CrossRef] [PubMed]
- Darwesh, O.M.; El-Hawary, A.S.; El Kelany, U.S.; El-Sherbiny, G.M. Nematicidal Activity of Thermostable Alkaline Protease Produced by Saccharomonospora Viridis Strain Hw G550. Biotechnol. Rep. 2019, 24, e00386. [Google Scholar] [CrossRef]
- Dhindwal, A.S.; Lather, B.P.S.; Singh, J. Efficacy of Seed Treatments on Germination. Seedling Emergence and Vigour of Cotton (Gossypium hirsutum) Genotypes. Seed Res. 1991, 19, 59. [Google Scholar]
- Özkara, A.; Akyıl, D.; Erdoğmuş, S.F.; Konuk, M. Evaluation of Germination, Root Growth and Cytological Effects of Wastewater of Sugar Factory (Afyonkarahisar) Using Hordeum Vulgare Bioassays. Environ. Monit. Assess. 2011, 183, 517–524. [Google Scholar] [CrossRef] [PubMed]

| Medium | Growth | Aerial Mycelium | Substrate Mycelium | Diffusible Pigment |
|---|---|---|---|---|
| ISP-1 | Good | White | Yellow | No |
| ISP-2 | Good | Grey | Light brown | No |
| ISP-3 | Very good | Grey | Brown | No |
| ISP-4 | Very good | Grey | Brown | No |
| ISP-5 | Good | Hygroscopic growth (without sporulation) | Yellow | No |
| ISP-6 | Good | Hygroscopic growth (without sporulation) | Yellow | No |
| ISP-7 | Very good | Light grey | Light brown | No |
| Utilization of Carbon Sources | Results | NaCl Tolerance (%) | Results |
|---|---|---|---|
| D-Glucose | ++ | 0 | + |
| L-Rhamnose | ++ | 1 | ++ |
| D-Xylose | ++ | 2 | ++ |
| D-Mannitol | ++ | 3 | ++ |
| Inositol | ++ | 4 | ++ |
| Sucrose | + | 5 | ++ |
| L-Arabinose | ++ | 6 | + |
| Fructose | ++ | 7 | + |
| Cellulose | + | 8 | − |
| Growth at different temperatures (°C) | Utilization of nitrogen sources | ||
| 10 | − | L-Asparagine | + |
| 20 | + | L-Cysteine | − |
| 30 | ++ | L-Valine | + |
| 40 | ++ | L-Threonine | + |
| 50 | + | L-Phenylalanine | ++ |
| 60 | − | L-Methionine | + |
| Growth at different pH values | L-Histidine | ++ | |
| 4 | − | L-Arginine | ++ |
| 5 | + | Tolerance to toxic substances | |
| 6 | + | Sodium azide 0.01% (w/v) | − |
| 7 | ++ | Phenol 0.1% (w/v) | − |
| 8 | ++ | Crystal violet 0.001% (w/v) | ± |
| 9 | + | Growth on Czapek’s medium | ± |
| 10 | − | ||
| No. | Biochemical Tests | Results |
|---|---|---|
| 1 | Lipid hydrolysis | + |
| 2 | Starch hydrolysis | + |
| 3 | Gelatin hydrolysis | + |
| 4 | Casein hydrolysis | − |
| 5 | Tyrosine degradation | + |
| 6 | Urea degradation | + |
| 7 | Pectin degradation | + |
| 8 | Esculin degradation | + |
| 9 | Citrate utilization | + |
| 10 | Motility test | − |
| 11 | H2S production | − |
| 12 | Lecithin degradation | + |
| No. | Microorganisms | Mean Diameter of Inhibition Zone (mm) ± Std. Error | MIC (µg/mL) | ||
|---|---|---|---|---|---|
| ZnO-NP Nanofluid | Base Fluid | Control AB | |||
| 1 | Erwinia amylovora | 26.6 ± 0.667 | 0 | SXT 19.6 ± 0.667 | 15.6 |
| 2 | Aspergillus flavus | 17.6 ± 0.667 | 0 | FLU 0 | 250 |
| 3 | Aspergillus niger | 15 | 0 | FLU 0 | 125 |
| 4 | Fusarium oxysporum | 21 ± 0.577 | 0 | FLU 0 | 62.5 |
| 5 | Fusarium moniliform | 22 ± 0.577 | 0 | FLU 17.6 ± 0.882 | 250 |
| 6 | Alternaria alternata | 17 ± 0.667 | 0 | FLU 0 | 500 |
| 7 | Aspergillus oryzae | 18.3 ± 0.882 | 0 | FLU 0 | 250 |
| 8 | Aspergillus fumigatus | 17.3 ± 0.667 | 0 | FLU 0 | 250 |
| Treatments | Time | Mitotic Index | Prophase Index | Metaphase Index | Ana Phase Index | Telophase Index |
|---|---|---|---|---|---|---|
| D.W | 2 | 14.93 ± 0.9 | 37.55 ± 2.9 | 28.18 ± 4.67 | 19.90 ± 3.6 | 4.36 ± 4.2 |
| 4 | 14.93 ± 0.9 | |||||
| 6 | 14.93 ± 0.9 | |||||
| Base 12.5 | 2 | 18.53 ± 4.0 | 45.44 ± 3.0 | 33.30 ± 3.33 | 13.50 ± 3.5 | 7.750 ± 1.87 |
| 4 | 14.7 ± 2.8 | |||||
| 6 | 11.6 ± 1.2 | |||||
| 12.5 µg/mL | 2 | 28.73 ± 3.0 | 48.42 ± 3.0 | 26.61 ± 5.53 | 15.12 ± 5.07 | 9.82 ± 2.31 |
| 4 | 20.06 ± 1.0 | |||||
| 6 | 13.66 ± 1.0 | |||||
| Base 25 | 2 | 16.86 ± 1.0 | 50.68 ± 4.0 | 26.21 ± 3.9 | 15.68 ± 3.7 | 7.42 ± 2.59 |
| 4 | 14.6 ± 1.9 | |||||
| 6 | 7 ± 2 | |||||
| 25 µg/mL | 2 | 17.76 ± 1.0 | 45.31 ± 6.5 | 27.88 ± 7.5 | 12.09 ± 2.5 | 14.70 ± 2.03 |
| 4 | 14.7 ± 1.5 | |||||
| 6 | 7.36 ± 1.5 | |||||
| Base 50 | 2 | 17.4 ± 2.8 | 38.69 ± 3.5 | 31.81 ± 2.8 | 11.46 ± 2.3 | 18.02 ± 1.81 |
| 4 | 14.5 ± 1,8 | |||||
| 6 | 5.2 ± 0.55 | |||||
| 50 µg/mL | 2 | 17 ± 1.4 | 41.62 ± 7.9 | 24.45 ± 2.9 | 10.81 ± 4.97 | 23.09 ± 4.54 |
| 4 | 17.36 ± 1.0 | |||||
| 6 | 11.26 ± 2.0 | |||||
| Base 100 | 2 | 4.8 ± 1.01 | 0 ± 0 | 66.55 ± 2.8 | 25.20 ± 3.53 | 8.24 ± 0.73 |
| 4 | 3 ± 0.90 | |||||
| 6 | 2.8 ± 1.01 | |||||
| 100 µg/mL | 2 | 7.93 ± 0.5 | 15.65 ± 5.8 | 34.02 ± 4.1 | 36.06 ± 5.17 | 14.26 ± 4.35 |
| 4 | 4.93 ± 1.7 | |||||
| 6 | 2.9 ± 0.85 | |||||
| Base 200 | 2 | 2.93 ± 0.6 | 0 ± 0 | 42.56 ± 9.1 | 25.01 ± 5.13 | 32.41 ± 10.3 |
| 4 | 2 ± 0.55 | |||||
| 6 | 2.1 ± 0.36 | |||||
| 200 µg/mL | 2 | 5 ± 0.60 | 0 ± 0 | 22.01 ± 5.45 | 35.09 ± 8.69 | 42.88 ± 6.87 |
| 4 | 4.3 ± 1.3 | |||||
| 6 | 2.5 ± 0.7 |
Publisher’s Note: MDPI stays neutral with regard to jurisdictional claims in published maps and institutional affiliations. |
© 2021 by the authors. Licensee MDPI, Basel, Switzerland. This article is an open access article distributed under the terms and conditions of the Creative Commons Attribution (CC BY) license (https://creativecommons.org/licenses/by/4.0/).
Share and Cite
Kalaba, M.H.; Moghannem, S.A.; El-Hawary, A.S.; Radwan, A.A.; Sharaf, M.H.; Shaban, A.S. Green Synthesized ZnO Nanoparticles Mediated by Streptomyces plicatus: Characterizations, Antimicrobial and Nematicidal Activities and Cytogenetic Effects. Plants 2021, 10, 1760. https://doi.org/10.3390/plants10091760
Kalaba MH, Moghannem SA, El-Hawary AS, Radwan AA, Sharaf MH, Shaban AS. Green Synthesized ZnO Nanoparticles Mediated by Streptomyces plicatus: Characterizations, Antimicrobial and Nematicidal Activities and Cytogenetic Effects. Plants. 2021; 10(9):1760. https://doi.org/10.3390/plants10091760
Chicago/Turabian StyleKalaba, Mohamed H., Saad A. Moghannem, Ahmad S. El-Hawary, Ahmed A. Radwan, Mohamed H. Sharaf, and Abdelghany S. Shaban. 2021. "Green Synthesized ZnO Nanoparticles Mediated by Streptomyces plicatus: Characterizations, Antimicrobial and Nematicidal Activities and Cytogenetic Effects" Plants 10, no. 9: 1760. https://doi.org/10.3390/plants10091760
APA StyleKalaba, M. H., Moghannem, S. A., El-Hawary, A. S., Radwan, A. A., Sharaf, M. H., & Shaban, A. S. (2021). Green Synthesized ZnO Nanoparticles Mediated by Streptomyces plicatus: Characterizations, Antimicrobial and Nematicidal Activities and Cytogenetic Effects. Plants, 10(9), 1760. https://doi.org/10.3390/plants10091760

